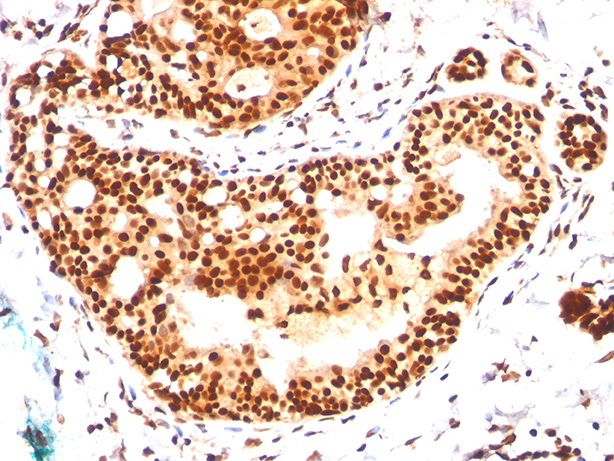

> Antigen, Antibodies, ELISA, Western Blot > Primary Antibody > Monoclonal Antibodies > SUMO-2/3 Antibody - With BSA and AzideBrand |
Leading Biology | Catalog Number |
AMM00185G |
Product Type |
Monoclonal Antibodies | Field of Research |
|
Product Overview |
We constantly strive to ensure we provide our customers with the best antibodies. As a result of this work we offer this antibody in purified format.
We are in the process of updating our datasheets. If you have any questions regarding this update, please feel free to contact our technical support team.
This product is a high quality SUMO-2/3 Antibody - With BSA and Azide.
|
||
Molecular Weight |
11-13kDa
|
||
Cellular Localization |
Antigen Cellular Localization:
Nucleus. Nucleus, PML body.
|
||
Host |
Mouse
|
||
Species Reactivity |
Human
|
||
Target |
Recombinant human SUMO2 protein
|
||
Clone |
SM23/496
|
||
Isotype |
IgG1, kappa
|
||
GeneID |
|||
UniProt ID |
|||
Function |
Ubiquitin-like protein that can be covalently attached to proteins as a monomer or as a lysine-linked polymer. Covalent attachment via an isopeptide bond to its substrates requires prior activation by the E1 complex SAE1-SAE2 and linkage to the E2 enzyme UBE2I, and can be promoted by an E3 ligase such as PIAS1-4, RANBP2 or CBX4. This post-translational modification on lysine residues of proteins plays a crucial role in a number of cellular processes such as nuclear transport, DNA replication and repair, mitosis and signal transduction. Polymeric SUMO2 chains are also susceptible to polyubiquitination which functions as a signal for proteasomal degradation of modified proteins.
|
||
Summary |
This MAb reacts with both SUMO-2 and SUMO-3. The small ubiquitin-related modifier (SUMO) proteins, which include SUMO-1, 2 and 3, belong to the ubiquitin-like protein family. Like ubiquitin, the SUMO proteins are synthesized as precursor proteins that undergo processing before conjugation to target proteins. Also, both utilize the E1, E2 and E3 cascade enzymes for conjugation. However, SUMO and ubiquitin differ with respect to targeting. Ubiquitination predominantly targets proteins for degradation, whereas sumoylation targets proteins to a variety of cellular processing, including nuclear transport, transcriptional regulation, apoptosis and protein stability. The unconjugated SUMO-1, 2 and 3 proteins localize to the nuclear membrane, nuclear bodies and cytoplasm, respectively. SUMO-1 utilizes Ubc9 for conjugation to several target proteins, which include MDM2, p53, PML and RanGap1. SUMO-2 and 3 contribute to a greater percentage of protein modification than does SUMO-1 and unlike SUMO-1, they can form polymeric chains. In addition, SUMO-3 regulates beta-Amyloid generation and may be critical in the onset or progression of Alzheimer’s disease.
|
||
Form |
Liquid. Purified antibody supplied in 1x PBS buffer with 0.09% (w/v) sodium azide and 2% sucrose. |
||
Storage & Stability |
Store at +4°C short term. For long-term storage, aliquot and store at -20°C or below. Stable for 12 months at -20°C. Avoid repeated freeze-thaw cycles.
|
||
Applications |
WB, IHC, FC, IP, E
|
||
Images |
Formalin-fixed, paraffin-embedded human tonsil stained with SUMO-2 MAb (SM23/496) |
||
Specification |
|||
Quantity |
|
||
| Select | Brand | Catalog No. | Product Name | Pack Size | Type | Field of Research | Specification | Quantity | Price(USD) | |
| 1 | Leading Biology | APG02467G | CCK4 / PTK7 Antibody (clone 4F9) | 50 μl | Monoclonal Antibodies |
|
$495.00 | Add Ask | ||
| 2 | Leading Biology | AMM04683G | GALT Antibody (clone 4C11) | 50 μg | Monoclonal Antibodies |
|
$545.00 | Add Ask | ||
| 3 | Leading Biology | AMM01402G | Vimentin (Mesenchymal Cell Marker) Antibody - With BSA and Azide | 50 ug | Monoclonal Antibodies |
|
$395.00 | Add Ask | ||
| 4 | Leading Biology | APR08280G | LTA4H / LTA4 Antibody (clone 9G8) | 50 μl | Monoclonal Antibodies |
|
$495.00 | Add Ask | ||
| 5 | Leading Biology | AMM00172G | CD1a / HTA1 (Mature Langerhans Cells Marker) Antibody - With BSA and Azide | 50 ug | Monoclonal Antibodies |
|
$395.00 | Add Ask | ||
| 6 | Leading Biology | AMM05750G | CEBPA Antibody | 100 μl | Monoclonal Antibodies |
|
$545.00 | Add Ask |
 Leading Biology Inc.
2600 Hilltop DR, Building G, B Suite C138
Richmond, CA, 94806
Tel: 1-661-524(LBI)-0262
Email: info@leadingbiology.com
Leading Biology Inc.
2600 Hilltop DR, Building G, B Suite C138
Richmond, CA, 94806
Tel: 1-661-524(LBI)-0262
Email: info@leadingbiology.com
Complete this form and click send to ask us a question, request a quote or simply say hello.

You have 0 item in your cart

You have 0 item in your inquiry list
